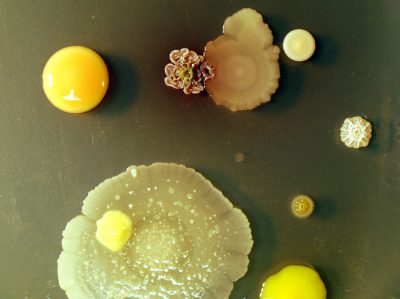
9 - VJC2_LifeonEarth

Life on Earth: an abstract picture
Publicada el 8/03/2026
Título: Life on Earth: an abstract picture
Autor: Víctor Jiménez Cid
Dpto. Microbiología II, Facultad de Farmacia. Universidad Complutense de Madrid. 28040-Madrid, Spain
Descripción: A 1000-fold dilution of a soil sample on tryptose-soy agar provides a peculiar landscape in which a dozen of microbial species thrive. Bacterial colonies were shot with the help of extension rings after one week of incubation at room temperature.